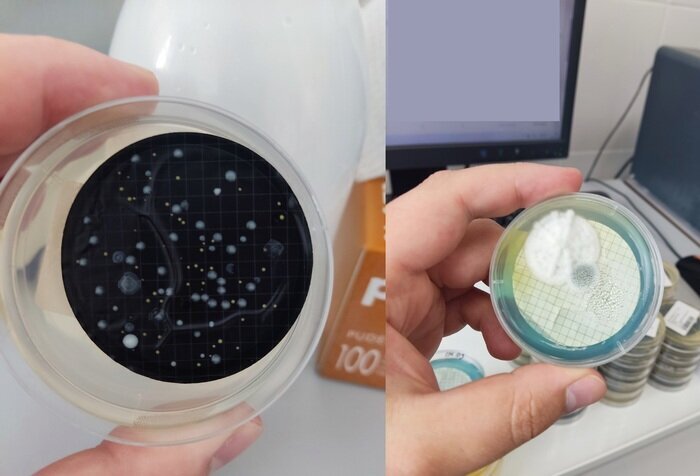

Короли биосферы. Классификация грибов
В прошлый раз мы разглядывали люминесцентные грибы, а сегодня наведу на тебя зевоту и скучным понятием "классификация". Так что грИби сюда, будем зевать вместе.
Начнём с того, что классификации у грибов нет 🤷♂️. Ладно, общепринятой нет. Но так как все мы - немного Карл Линней, то классифицировать надо даже неклассифицируемое.
Напоминалка:
Мицелий, или грибница - вегетативное тело грибов и актиномицетов, состоящее из тонких (1,5-10 мкм толщиной у грибов и 0,5-1,0 мкм у актиномицетов) разветвлённых нитей, называемых гифами. Развивается в субстрате и на его поверхности.
Короче, на вид сеть такая, как на микроскопическом уровне, так и вполне видимом невооруженным глазом.
Таксон - группа в классификации, состоящая из дискретных объектов, объединяемых на основании общих свойств и признаков.
А теперь вот тебе систематика грибов по способу размножения:
Хитридиомицеты - плазмодий (род паразитических простейших, клетка, образовавшаяся не путём слияния нескольких клеток, а путём деления ядра исходной одноядерной клетки), вегетативное размножение не обнаружено, одножгутиковые зооспоры, полового спороношения нет, гаметы подвижны, изо- или гетерогамия, все представители - паразиты.
Объединяет более 120 родов и около 1000 видов. Мицелий слабо развит, основная масса представляет собой плазмодий, из которого вырастают ризоидные гифы. Самые примитивные представители совершенно не имеют мицелия, и тело их в вегетативном состоянии представлено одиночной клеткой, иногда лишённой жёсткой клеточной стенки. Основа клеточной стенки хитиново-глюкановая, как и у высших грибов.
Вот такие вкусняшки с самого начала.
Поскольку в жизненном цикле хитридиомицетов присутствуют жгутиковые зооспоры, в конце 1980-х - 1990-х годах многие исследователи исключали их из царства грибов и относили к грибоподобным хромистам (лучше не начинать разбирать, что это такое). Примерно в то же время (1991—1996) появились данные по ультраструктуре митохондрий, химическому составу клеточных стенок и молекулярно-филогенетические анализы этих организмов, которые показали, что их всё же следует относить к настоящим грибам.
Зигомицеты - отдел грибов, объединяющий 10 порядков, 27 семейств, около 170 родов и более 1 000 видов. Отличаются развитым ценоцитным мицелием непостоянной толщины, в котором септы (разделённые области клетки) образуются только для отделения репродуктивных органов. Способность к почкованию, бесполое размножение спорангиоспорами.
Аскомицеты или сумчатые грибы - отдел в царстве грибов, объединяющий организмы с септированным (разделённым на клетки) мицелием и специфическими органами полового спороношения - сумками (асками), содержащими чаще всего по 8 аскоспор. Имеют и бесполое спороношение, причём во многих случаях половой процесс утрачивается.
Характерен хорошо развитый многоклеточный гаплоидный мицелий, способность к почкованию и образованию склероций (продолговатые или округлые тела различной формы и величины, состоящие из тесно сплетённых нитей мицелия грибов и составляющие стадию покоя гриба, возникающую в неблагоприятных условиях для их переживания), конидии (неподвижные споры бесполого размножения у грибов. При благоприятных условиях развиваются в новый организм и способствуют распространению, то есть служат как для размножения, так и для расселения).
Аскомицеты представляют собой одну из самых многочисленных групп грибов - более 32 000 видов (~30 % всех известных науке видов грибов). Их отличает огромное разнообразие - от микроскопических почкующихся форм до обладающих очень крупными плодовыми телами грибов.
Базидиомицеты- отдел из царства грибов, включающий виды, производящие споры в булавовидных структурах, именуемых базидиями. Вместе с аскомицетами составляют подцарство высших грибов (Dikarya).
Группа включает подавляющее большинство грибов, употребляемых человеком в пищу, а также ядовитых грибов и многих паразитов культурных и диких растений. Всего насчитывается свыше 30 000 видов.
Мицелий базидиомицетов септирован, каждая клетка содержит по два гаплоидных ядра. Обычно ядра расположены рядом посередине клетки, их пара носит название дикарион. Возле септы на гифах большинства базидиомицетов формируется пряжка, участвующая в делении клетки. Пряжка - тонкий вырост из одной клетки гриба, примыкающий к другой соседней клетке. При делении клетки ядра синхронно удваиваются и пряжка позволяет оказаться в одной клетке ядрам, сформировавшимся из разных исходных.
Вся поверхность плодового тела, несущая гимениальный слой, называется гименофором. У низших форм он остаётся гладким, а у более высокоорганизованных образует пластинки, трубочки или шипы.
Дейтеромицеты - (также несовершенные грибы , анаморфные грибы) - грибы, размножающиеся посредством пропагул, образующихся без участия процессов мейотического деления. Как правило, эти пропагулы представляют собой конидии, реже образуются из недифференцированного мицелия. В эту гетерогенную группу объединены все грибы с развитым мицелием, размножающиеся частями мицелия и конидиями (неподвижные споры бесполого размножения у грибов) и с неизвестным до настоящего времени половым процессом. Насчитывается около 30 000 видов.
Многие дейтеромицеты представляют стадии жизненного цикла совершенных аскомицетовых и базидиомицетовых грибов и при некоторых условиях переходят в стадию, способную образовывать споры в процессе мейоза. У многих дейтеромицетов совершенная форма, вероятно, существует, однако пока не определена.
Типичные представители - аспергиллы, пенициллы.
Отдельно стоит отметить дрожжи - внетаксономическая группа одноклеточных грибов, утративших мицелиальное строение в связи с переходом к обитанию в жидких и полужидких, богатых органическими веществами субстратах. Объединяет около 1500 видов, относящихся к отделам аскомицетов и базидиомицетов.
Для практического применения важны продукты вторичного метаболизма дрожжей, выделяемые в малых количествах в среду: сивушные масла, ацетоин (ацетилметилкарбинол), диацетил, масляный альдегид, изоамиловый спирт, диметилсульфид и др. Именно от них зависят органолептические свойства полученных с помощью дрожжей продуктов.
Спасибо за то, что уделяешь время на прочтение этого таксономического ада. В свободное время забегай на другие мои статьи.